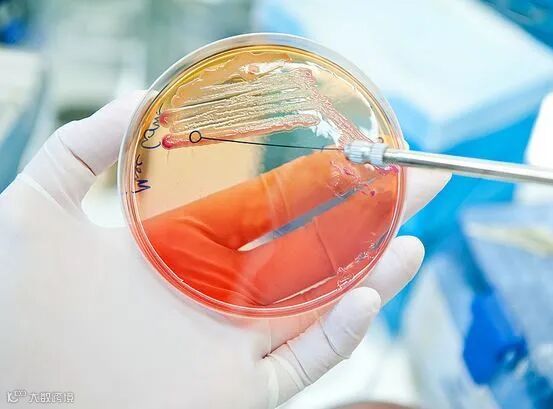

疫苗类型
疫苗类型 |
作用机理 |
活的、致弱 · 重组载体
|
活的微生物只是被致弱了,限制了致病力。是免疫系统的好老师。一生的免疫可通过1或2剂实现。通常需要冷藏,保质期短。使用减毒形式来模拟病毒如何锁定细胞,将遗传物质注入其中。科学家们提取无害或减毒病毒的基因组,将来自其他微生物的部分遗传物质插入其中,然后将微生物DNA转移到细胞中—这是一种良好的免疫刺激。 |
灭活苗/死苗 |
病原体可被热、化学物质或辐射杀死,因此它们无法回到致病状态。大多数会引发较弱的免疫反应,可能需要加强免疫。 |
类毒素(灭活内毒素) |
用于分泌毒素/化学物质的细菌。毒素可以用甲醛溶液灭活。通过接种类毒素来训练机体对毒素做出反应。 |
亚单位 · 结合
|
使用的是相关抗原,而不是整个病原体,降低了对疫苗产生不良反应的机会。当细菌由多糖外壳组成时可能是答案。这种涂层通过伪装细菌抗原来躲避未成熟的免疫系统。这些疫苗通过与多糖结合的可识别抗原或类毒素来解决这一问题。 |
DNA |
是一类很有发展前景的疫苗。一旦对微生物的基因进行了研究,科学家就可以制造出一种对抗微生物的DNA疫苗。设计和生产相对便宜,它们不需要机体的某些部分,而是向细胞提供制造抗原分子的指令,然后细胞分泌抗原,自己生产疫苗。 |
家禽饲养策略已经改变以控制胃肠道微生物
美国东北大学的微生物学家收到了发现泰斯巴汀的全球报道。虽然对哺乳动物细胞无害,但它攻击革兰氏阳性病原体,如金黄色葡萄球菌、肠球菌和结核分枝杆菌。
此外,通过名为“芯片”的微型装置创造理想的细菌环境的发现方法也值得注意。芯片可以在自然环境中分离并促进单细胞的生长,这可能会让科学家研究更多的微生物。
这可能是一条发现更多药物的途径。促进非培养细菌生长让科学家有机会分析更多未开发的微生物,在当前的健康危机下,这可能非常有用。
来源:网络搜集,如涉及侵权,请联系删除。


